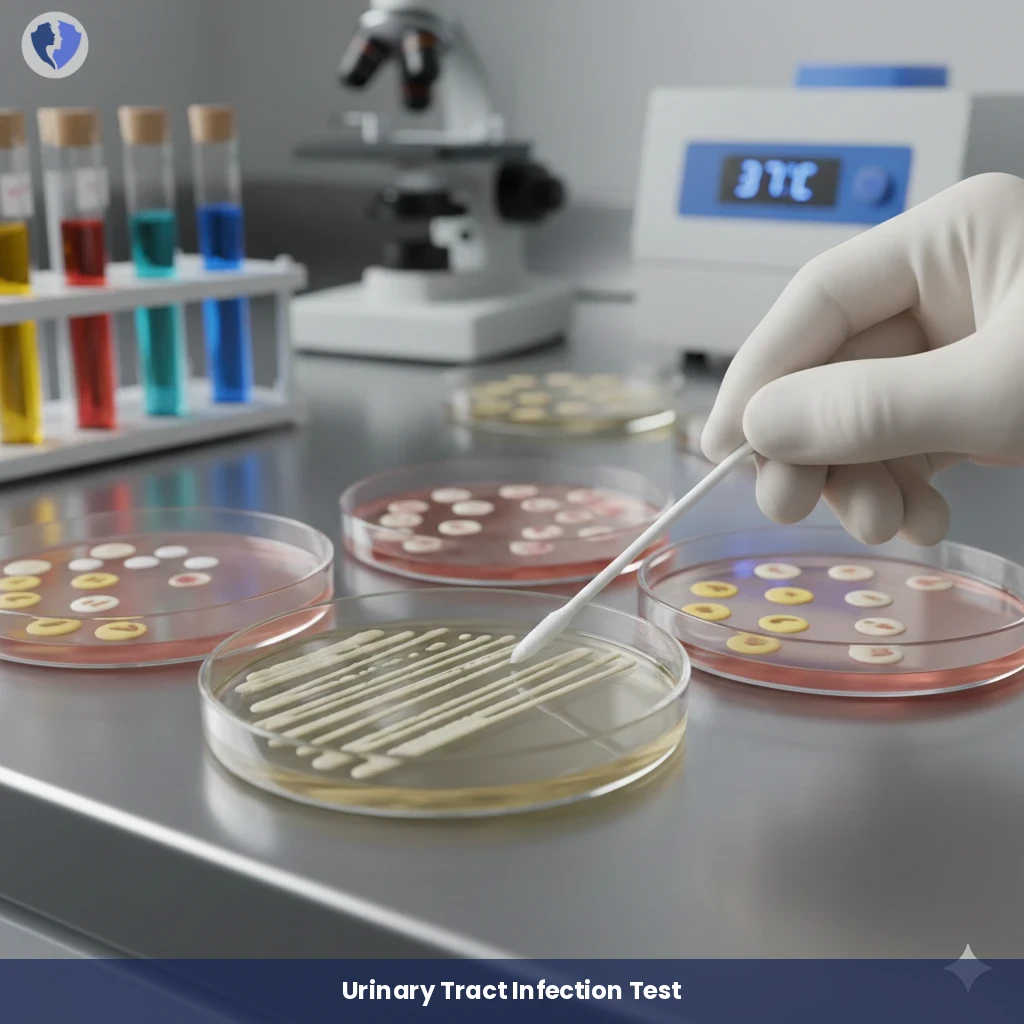
Urethral Swab Culture Test - Urethral Swab Culture and Sensitivity

Service Details
Urethral Swab Culture Test - Urethral Swab Culture and Sensitivity
A microbiological examination involves collecting a sample from inside the urethra (urinary tract) using a special thin, sterile swab. Culture aims to isolate and identify the bacteria causing urethritis, which may include sexually transmitted pathogens (such as Neisseria gonorrhoeae, Chlamydia trachomatis) or other bacteria (such as E. coli, Enterococcus). After identifying the bacteria, antibiotic sensitivity testing is performed to determine the most appropriate treatment. This is the primary test for diagnosing bacterial urethritis, especially in males.